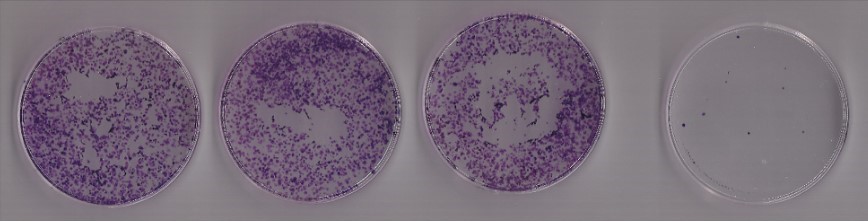
سنجش کلونوژنیک

مقدمهای بر سنجش کلونوژنیک
سنجش کلونوژنیک به عنوان ابزار مفیدی برای آزمایش اینکه آیا یک درمان سرطان معین میتواند بقای کلونوژنیک سلولهای تومور را کاهش دهد، عمل میکند.
کلنی به عنوان خوشه ای متشکل از حداقل 50 سلول تعریف می شود که اغلب فقط می توان آن را به صورت میکروسکوپی تعیین کرد. روش کلونوژنیک روش انتخابی برای تعیین مرگ باروری سلولی پس از درمان با پرتوهای یونیزان است، اما می تواند برای تعیین اثربخشی سایر عوامل سیتوتوکسیک نیز استفاده شود. پروتکل زیر از نسخه منتشر شده اصلاح شده است.
مراحل انجام سنجش کلونوژنیک
مرحله اول: کندن سلولی
- سلول ها را بر اساس نیاز کشت دهید
- محیط را دور ریخته و سپس سلول ها را با PBS شستشو دهید.
- به ازاء هر cm ۲۵ ، cc۱ تریپسین به سلول ها اضافه کنید و در دمای ۳۷ درجه سانتی گراد به مدت ۱- ۵ دقیقه انکوبه کنید تا سلول ها گرد ظاهر شوند.
- دو برابر مقدار تریسین محیط کشت اضافه می کنیم تا تریسین خنثی شود
- محلول را در فالکون ریخته و سانتریفیوژ میکنیم
- محیط رویی را دور ریخته و به یلت ایجاد شده ml ۱ محیط کشت اضافه کرده و پیپتاژ می کنیم
- با استفاده از هموسیتومتر سلول ها را بشمارید.
مرحله دوم: seeding
- سلول ها را جمع آوری کنید و تعداد مناسبی(۱۰۰ الی ۱۰۰۰) از سلول ها را در هر ظرف یا هر چاه روی یک صفحه ۶ چاهی بکارید. سلول ها را برای۲۴ ساعت در انکوباتور CO2 در دمای ۳۷ درجه سانتیگراد انکوبه کنید و اجازه دهید به پلیت بچسبند.
- سلول ها را با دارو تیمار کنید
سلول ها را در انکوباتور CO2 در دمای ۳۷ درجه سانتیگراد به مدت ۱-۳ هفته انکوبه کنید تا زمانی که سلول های موجود در صفحات شاهد کلنی هایی با اندازه قابل ملاحظه ای خوب تشکیل دهند (50 سلول در هر کلنی).

مرحله سوم: رنگ آمیزی
- محیط را دور بریزید و سپس سلول ها را با PBS شستشو دهید.
- PBS را دور بریزید و ۲-۳میلی لیتر محلول تثبیت کننده (فرمالدهید) اضافه کنید و پلیتها را به مدت ۵ دقیقه در دمای اتاق (RT) بگذارید.
- فرمالدهید را دوربریزید
- محلول کریستال ویوله ۰.۵% را اضافه کنید و به مدت ۳۰ دقیقه در RT انکوبه کنید.
- کریستال ویوله را دور ریخته و شست و شو دهید
- حال هم با چشم غیر مسلح و هم با میکروسکوب نوری کلنی ها قابل مشاهده هستند
مطالب مرتبط با سنجش کلونوژنیک:
- دوره مهارت آموزی کشت سلول
- سنجش میزان اثر سمیت مواد
- دیفریز سلول، پاساژ و فریز کردن سلول ها
- رنگ آمیزی Acridine orange/Propidium iodide
نویسنده: مهرداد ایزدیراد





